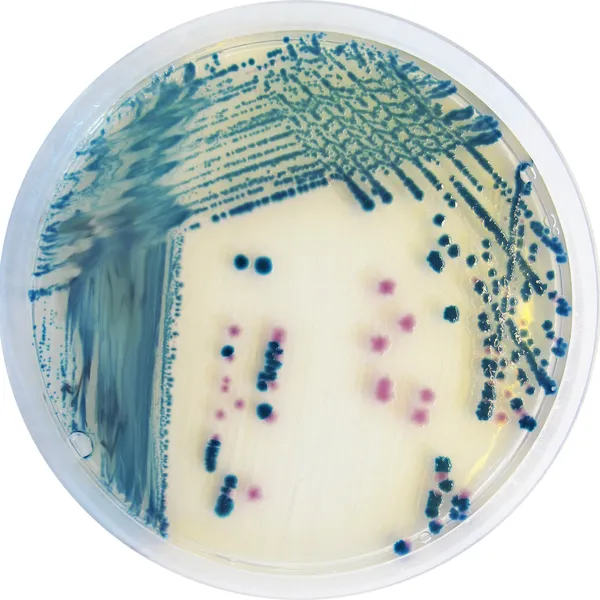
CHROMagar™ Y. enterocolitica

Colonies Appearance

Pathogenic Y. enterocolitica
Mauve

Non pathogenic Y. enterocolitica and background flora (Citrobacter, Enterobacter, Aeromonas etc)
Metallic blue, inhibited or limited growth in metallic blue colour
Performance
Performance
Among the Yersinia genus, Yersinia enterocolitica is one of the most common food borne pathogen. In several countries, Y. enterocolitica has eclipsed Shigella and approaches Salmonella and Campylobacter as the predominant cause of acute bacterial gastroenteritis. Its ability to grow at refrigeration temperature makes it an increasing concern in terms of food safety. This germ most commonly affects young individuals. However, only a few strains of Y. enterocolitica cause illness in humans. Those pathogenic Y. enterocolitica strains belong to biotypes 1B, 2, 3, 4, and 5, whereas biotype 1A strains are non-pathogenic and widespread in the environment. The major animal Y. enterocolitica reservoir causing illnesses are pigs.
Intended Use :
CHROMagar™ Y.enterocolitica is a selective chromogenic culture medium intended for use in the qualitative direct detection, differentiation and presumptive identification of pathogenic biotypes of Yersinia enterocolitica. The test is performed with rectal swabs and stools, to aid in the diagnosis of Y. enterocolitica infections. Results can be interpreted after 36-48 h of aerobic incubation at 30 °C ± 2 °C.
Concomitant cultures are necessary to recover organisms for further microbiological testing or epidemiological typing. A lack of growth or the absence of colonies on CHROMagar™ Y.enterocolitica does not preclude the presence of Y. enterocolitica. CHROMagar™ Y.enterocolitica is not intended to diagnose infection nor to guide nor monitor treatment for infections. CHROMagar™ Y.enterocolitica can also be used in the detection of Y. enterocolitica in the analyses of food products for human consumption, animal feed and in environmental samples.
Composition
Technical Documents
Scientific Publications
2018
Jämförelse av CIN-agar och CHROMagar™ Y. enterocolitica vid identifiering av humanpatogena Yersinia enterocolitica
? Publication2013
Comparison of CHROMagar Yersinia and CIN Agar media for isolation of potentially virulent Yersinia enterocolitica in stools
? Publication2013
Differentiation of Yersenia enterocolitica biotype 1A from pathogenic Yersenia enterocolitica biotypes by detection of B-glucosidase activity: comparison of two chromogenic culture media and Vitek2
? Publication2012
Comparison of CHROMagar Yersinia and CIN Agar media for isolation of potentially virulent Yersinia enterocolitica in stools
? Publication

Xem thêm